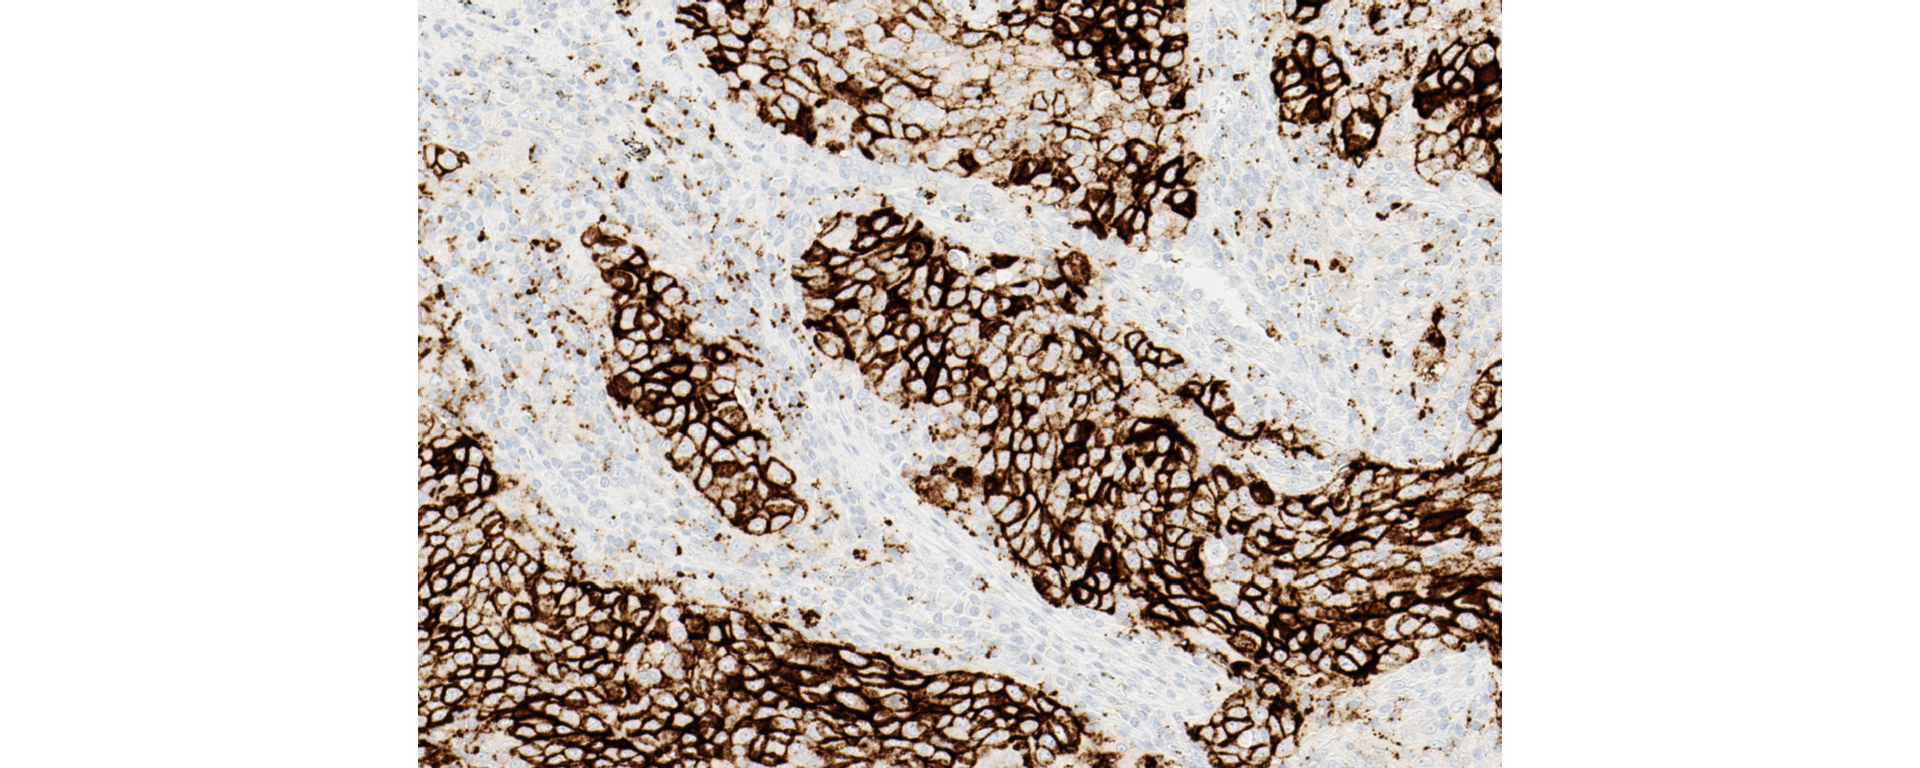
VENTANA PD-L1 SP142 IHC assay stain image

For localized information and support, would you like to switch to your country-specific website for {0}?
VENTANA® PD-L1 (SP142) Assay

Guiding immunotherapy decisions
VENTANA PD-L1 predictive assays identify patients who are most likely to respond to specific therapies, generating results you can trust so that you can make timely diagnostic decisions and therapeutic choices. We support your expertise by providing you with the tools that you need to successfully implement these assays into your laboratory and interpret them proficiently.
Empowering pathologists to answer PD-L1 questions
VENTANA PD-L1 (SP142) Assay* gives you the confidence to:
- Identify triple–negative breast cancer (TNBC) patients eligible for treatment with TECENTRIQ® (atezolizumab)
- Identify urothelial carcinoma (UC) patients eligible for treatment with TECENTRIQ (atezolizumab)
- Identify non-small cell lung cancer (NSCLC) patients eligible for first line treatment with TECENTRIQ (atezolizumab)
- Aid in the identification of NSCLC patients eligible for second line treatment with TECENTRIQ (atezolizumab)
* VENTANA PD-L1 (SP142) Assay may not be available for some indications and/or cutoffs in all geographies.
Companion diagnostic indications
Triple-negative breast cancer and urothelial carcinoma
Using the right test to determine PD-L1 status for immunotherapy options is important. VENTANA PD-L1 (SP142) Assay* is the first and only CE-IVD marked test for TECENTRIQ in triple–negative breast cancer (TNBC), urothelial carcinoma (UC) and non-small cell lung cancer (NSCLC) patients. This novel assay is also the first to evaluate patient PD-L1 expression using immune cell staining and scoring within the tumor microenvironment, providing you with information that can guide immunotherapy decisions.
VENTANA PD-L1 (SP142) Assay:
- Designed to enhance visual contrast of immune cell staining within the tumor microenvironment
- First PD-L1 assay CE-IVD marked with an immune cell scoring algorithm
- First and only PD-L1 assay clinically proven to identify patients eligible for and most likely to benefit from TECENTRIQ
Complementary diagnostic indications
Non-small cell lung cancer (NSCLC)
Using the right test to determine PD-L1 status for immunotherapy options is important, and the VENTANA PD-L1 (SP142) Assay is the only CE-IVD marked test for TECENTRIQ. This innovative assay is the first to evaluate patient PD-L1 expression using both tumor cell (TC) and tumor-infiltrating immune cell (IC) staining. Determining a patient’s PD-L1 expression level can give insight to the overall survival that may be achieved from TECENTRIQ.*
VENTANA PD-L1 (SP142) Assay:
- Only CE-IVD marked test to assess NSCLC patient treatment benefit from TECENTRIQ
- Informative for the clinician of a patient’s potential overall survival
- Novel scoring algorithm using PD-L1 staining in both TC and IC
- Designed to enhance visual contrast of immune cell staining within the tumor microenvironment
*NSCLC patient benefit observed from therapy with TECENTRIQ in a phase III clinical trial was independent of PD-L1 status.
Product specifications
VENTANA PD-L1 (SP142) Assay is intended for the immunohistochemical assessment of the programmed death-ligand 1 (PD-L1) protein in tumor cells and tumor-infiltrating immune cells in formalin-fixed, paraffin-embedded (FFPE) tissues indicated below stained with OptiView DAB IHC Detection Kit and OptiView Amplification Kit on a BenchMark IHC/ISH instrument.
Determination of PD-L1 status is indication-specific and evaluation is based on either the proportion of tumor area occupied by PD-L1 expressing tumor-infiltrating immune cells (% IC) of any intensity or the percentage of PD-L1 expressing tumor cells (% TC) of any intensity.
VENTANA PD-L1 (SP142) Assay companion diagnostic indications
View full tableVENTANA PD-L1 (SP142) Assay companion diagnostic indications
VENTANA PD-L1 (SP142) Assay is indicated as an aid for identifying patients for treatment with the therapies listed in this table for the respective indications and cutoffs in accordance with the approved therapeutic product labeling.
VENTANA PD-L1 (SP142) Assay is indicated as an aid for identifying patients for treatment with the therapies listed in this table for the respective indications and cutoffs in accordance with the approved therapeutic product labeling.
| Indication for use | Therapy |
Cutoff |
|---|---|---|
| Urothelial Carcinoma |
TECENTRIQ* |
≥ 5% IC |
| Triple–Negative Breast Carcinoma (TNBC) |
TECENTRIQ* | ≥ 1% IC |
| Non-small Cell Lung Cancer (NSCLC) | TECENTRIQ* | ≥ 50% TC or ≥ 10% IC |
VENTANA PD-L1 (SP142) Assay complementary diagnostic indication
View full tableVENTANA PD-L1 (SP142) Assay complementary diagnostic indication
VENTANA PD-L1 (SP142) Assay may be associated with enhanced patient benefit with the therapies listed in this table for the corresponding indication and cutoffs in accordance with the approved therapeutic product labeling.
VENTANA PD-L1 (SP142) Assay may be associated with enhanced patient benefit with the therapies listed in this table for the corresponding indication and cutoffs in accordance with the approved therapeutic product labeling.
| Indication for use | Therapy |
Cutoff |
|---|---|---|
| Non-small Cell Lung Cancer (NSCLC) | TECENTRIQ* | ≥ 50% TC or ≥ 10% IC |
| Non-small Cell Lung Cancer (NSCLC) | TECENTRIQ* | ≥ 1% TC or ≥ 1% IC |
* The international non-proprietary name (INN) for TECENTRIQ is atezolizumab.
Depending on therapeutic setting, PD-L1 expression in ≥ 50% TC or ≥ 10% IC determined by VENTANA PD-L1 (SP142) Assay in non-small cell lung cancer (NSCLC) patients may be associated with enhanced overall survival from TECENTRIQ (atezolizumab). Refer to the approved therapeutic product labeling for further information.
Test results of this product should be interpreted by a qualified pathologist in conjunction with histological examination, relevant clinical information, and proper controls.
This product is intended for in vitro diagnostic (IVD) use.